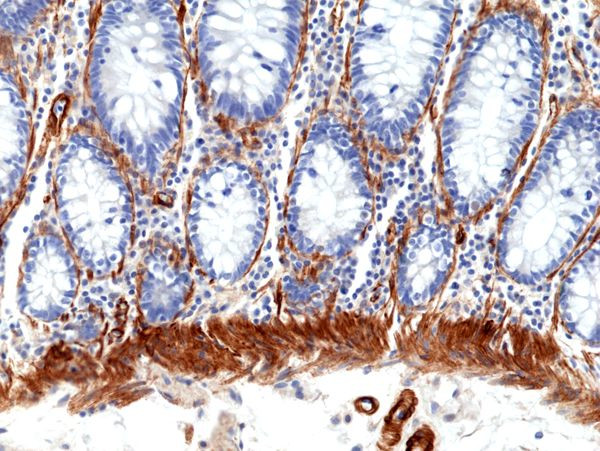
Caldesmon Antibody in Immunohistochemistry (Paraffin) (IHC (P))

Search
Invitrogen
Caldesmon Recombinant Rabbit Monoclonal Antibody (RM396)
{{$productOrderCtrl.translations['antibody.pdp.commerceCard.promotion.promotions']}}
{{$productOrderCtrl.translations['antibody.pdp.commerceCard.promotion.viewpromo']}}
{{$productOrderCtrl.translations['antibody.pdp.commerceCard.promotion.promocode']}}: {{promo.promoCode}} {{promo.promoTitle}} {{promo.promoDescription}}. {{$productOrderCtrl.translations['antibody.pdp.commerceCard.promotion.learnmore']}}
产品信息
MA5-36065
种属反应
宿主/亚型
Expression System
分类
类型
克隆号
抗原
偶联物
形式
浓度
规格
纯化类型
保存液
内含物
保存条件
运输条件
RRID
产品详细信息
This antibody may also react to mouse or rat CALD1, as predicted by immunogen homology.
靶标信息
Caldesmon is a developmentally regulated protein involved in smooth muscle and non muscle contraction. Two closely related variants of human caldesmon have been identified which differ in their electrophorectic mobility and cellular distribution. The h caldesmon variant (120 - 150 kDa) is predominantly expressed in smooth muscle whereas l caldesmon (70 - 80 kDa) is found in non-muscle tissue and cells. Neither of the two variants has been detected in skeletal muscle.
仅用于科研。不用于诊断过程。未经明确授权不得转售。
篇参考文献 (0)
生物信息学
蛋白别名: Caldesmon; CDM; MGC21352; OTTHUMP00000207950; OTTHUMP00000207953; OTTHUMP00000207954; OTTHUMP00000207955; OTTHUMP00000214473; testis secretory sperm-binding protein Li 227n; unnamed protein product
基因别名: CAD; CALD1; CDM; H-CAD; h-CD; HCAD; L-CAD; LCAD; NAG22
UniProt ID: (Human) Q05682
Entrez Gene ID: (Human) 800